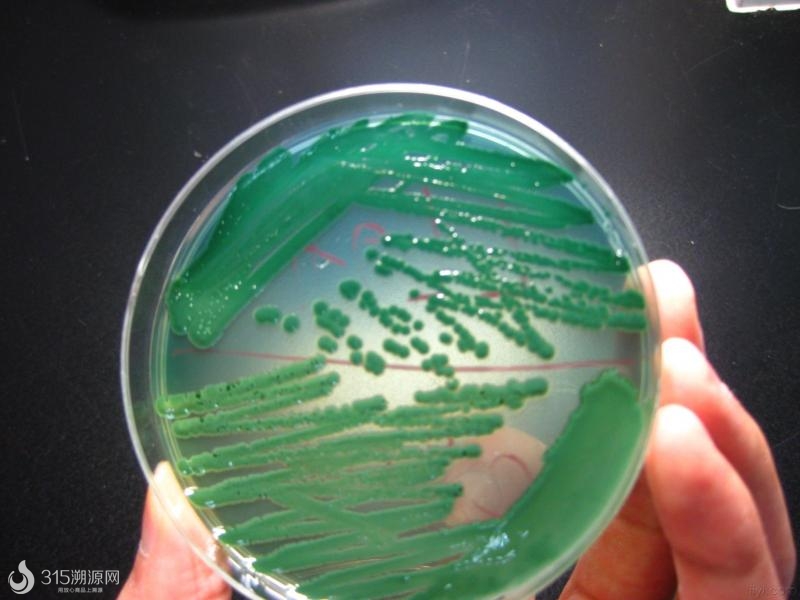
vibrio parahemolyticus

vibrio

an amino acid-decorated exopolysaccharide secreted by a vibrio
图片尺寸1080x1439
vibrio
图片尺寸500x400
预订 vibrio cholerae
图片尺寸332x499
vibrio parahemolyticus
图片尺寸684x196
【4周达】vibrio spp. infections
图片尺寸800x800
plymuthica,hahella chejuensis,pseudomonas magnesiorubra,vibrio
图片尺寸300x262
霍乱弧菌(vibrio cholerae)
图片尺寸452x280
它们能够与发光细菌"vibrio fischeri"形成共生关系,它在一个特殊的光
图片尺寸220x170
爆雷全国价格暴跌湖北潜江监利小龙虾又大量诡异死亡到
图片尺寸900x499
协和医生说|春节海边度假警惕"海洋中的隐匿杀手"
图片尺寸815x551
图3 mechanism of intestinal flora influencing vibrio cholerae
图片尺寸1034x1033
【预订】the biology of vibrios
图片尺寸328x425
vibrio parahemolyticus
图片尺寸800x600
vibrio parahemolyticus
图片尺寸547x436
其中, bdello一词来自希腊字,是水蛭的意思,vibrio意为弧菌
图片尺寸640x481
《医学微生物》课件 湘雅医学院出品 vibrio cholerae (霍乱弧菌)
图片尺寸1080x810
《病原学教研室》ppt课件
图片尺寸920x690
vibrio vulnificus
图片尺寸400x300
副溶血性弧菌(vibrio parahemolyticus)副溶血性弧菌也称为肠炎弧菌
图片尺寸1024x1024
第1种为弧菌,细胞短,不满一圈仅有一次弯曲,呈弧状,如脱硫弧菌(vibrio
图片尺寸439x293